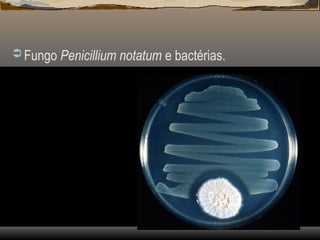
 Fungo Penicillium notatum e bactérias.

O documento aborda comportamentos de defesa animal, como anacorese, tanatose e fuga, e discute teorias evolutivas, incluindo a Teoria da Rainha Vermelha, que explica a coevolução entre espécies. Ele explora a seleção sexual, relações ecológicas como mutualismo, parasitismo e canibalismo, além de sucessões ecológicas primária e secundária. O texto destaca a importância das interações entre espécies para a sobrevivência e adaptação no ecossistema.